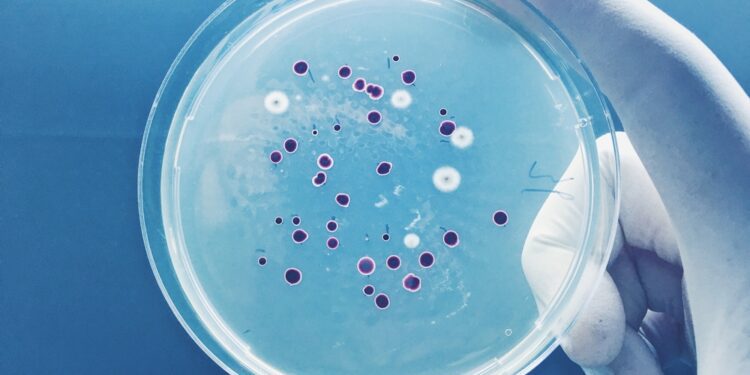

According to researchers from the University of Washington, methane-absorbing bacteria may have the potential to slow the global heating rate.
The researchers say that bacteria belonging to a group known as “methanotrophs’ are capable of “eating” methane and converting it into biomass and carbon dioxide.
If implemented at a large scale, the global heating rate could theoretically be reduced in turn.
However, spreading the use of this specific methane-absorbing bacteria across the world would reportedly require thousands of high-level reactors to function at an efficient level.